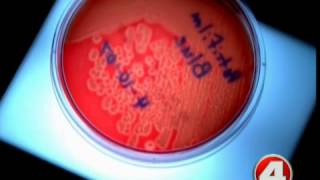

Officials probe E. coli outbreak in 6 states video
Online izle ve mp4 mp3 formatlarinda yukle
Videonun muddeti: 0:32
Officials probe E. coli outbreak in 6 states videosu mp4 ve mp3 yuklemek ucun hazirdir
Diqqet! Siz Mp4 yukle ve ya Mp3 yukle duymesine basdiqdan sonra eger sistem sizi reklam sehifesine atarsa o zaman derhal geri qayidib emeliyyati tekrar edin ve faylin yuklemek ucun hazir olmasini gozleyin
Videodan Mp4 Yukle
Videodan Mp3 Yukle-1
Videodan Mp3 Yukle-2
Oxshar Axtarishlar
Officials probe E. coli outbreak in 6 states
Lehi officials probe E. coli outbreak: grill health department for locations
Health officials: Throw away your Romaine lettuce after E. coli outbreak
Ground beef likely cause of 6-state E. Coli outbreak
At least 64 infected in E. coli outbreak tied to romaine lettuce
Health Officials Trying To Pinpoint Cause Of E.coli Outbreak Linked To Romaine Lettuce
Health officials warn E. coli outbreak linked to romaine lettuce
Health officials: Don't eat romaine lettuce due to a new E. coli outbreak
CDC Warns Romaine Lettuce May Be Linked To E. Coli Outbreak
Video Mp4 Mp3Azwap.Biz
Azwap.Biz 2021-2023